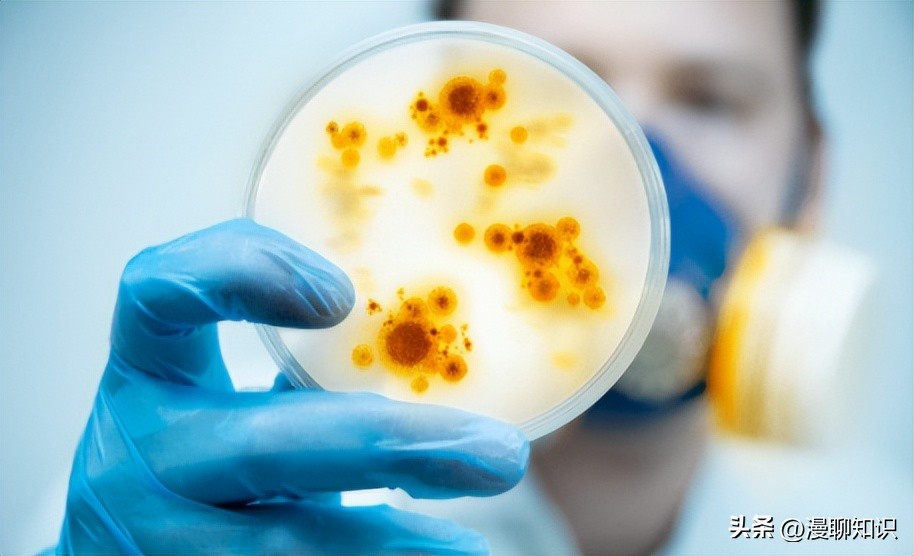
马传染性子宫炎传染性较强，它的传播途径有哪些

阅读文章前,辛苦您点下右上角的“关注”,方便您讨论分享,持续关注每日优质内容~
马传染性子宫炎(contagious equine metritis, CEM)是一种传染性较强的生殖系统疾病,主要危害繁殖期母马,会给马产业造成较大的经济损失,影响马属动物的国际贸易,被世界动物卫生组织(WOAH)列为必须通报的疫病之一。
CEM的病原为马生殖泰勒菌(Taylorella equigenitalis),该菌是一种革兰氏阴性菌,生长条件较为严苛,容易被其他细菌污染。
感染后的母马主要表现为脓性子宫炎和间情期缩短,公马感染后无临床症状且并不产生相关抗体。
迄今为止,该病尚无疫苗,检疫是控制此病的主要手段,可通过细菌学检查与分子生物学检查的方式对该病原菌进行检测,血清学方法也可作为一种辅助检测手段。

目前,虽然我国国内并未报道过该类病例,但随着马属动物养殖规模逐渐扩大,且马属动物的国际贸易及需求不断增加,因而该疾病也需引起广泛的重视。
迄今为止,国内对马传染性子宫炎的报道有限,对该病的研究尚处于空白状态。
因此,本文对马传染性子宫炎在国外的研究进展进行了论述,旨在为该病的诊断与预防提供一定参考。

马生殖泰勒菌是属于产碱杆菌科、泰勒菌属的一种革兰氏阴性、无动力球杆菌,无芽孢和鞭毛,但有丝样荚膜。
该菌呈现两端极染,长期培养的培养物可呈现多形性(可达6 μm长)。
本菌为兼性厌氧菌,最佳生长环境为37 ℃,5%~10%二氧化碳。
该菌对营养条件要求苛刻,在普通琼脂和普通肉汤培养基上几乎不生长,在马血或羊血尤刚(Eugon)巧克力琼脂以及胰蛋白胨巧克力琼脂上生长良好。
该菌的生长虽然不依赖于X(氯化血红素)、V(氧化型辅酶Ⅰ)和X+V因子,但X因子可以促进其生长。
在Eugon琼脂平板上培养48 h后,菌落直径为1~2 mm, 圆形,边缘整齐,灰色半透明,有光泽,呈露滴状。
在胰蛋白胨巧克力平板上培养48 h后,出现细小、圆形扁平或者隆起的灰色或者褐色菌落,菌落直径约为0.3~0.5 mm, 其大小小于Eugon琼脂平板上的菌落。

该菌对理化因子的抵抗力较弱,高温与一般消毒剂均可在短时间内杀死此菌。
本菌对氨苄西林、红霉素、氯霉素、土霉素、庆大霉素、卡那霉素 、多黏菌素B等多种抗菌药物敏感,对链霉素存在一定耐药现象。
根据该菌对链霉素的敏感程度可将其分为链霉素敏感菌与链霉素耐药菌。
Swerczek T W在肯塔基州分离得到链霉素耐药株与敏感株,并指出应该在现场即对该菌进行药物敏感性测试,因为该菌很容易适应实验室培养条件,从而对所添加药物产生耐药。
某些马生殖泰勒菌也对甲氧苄啶、磺胺甲恶唑和克林霉素耐药。

驴生殖泰勒菌(Taylorella asinigenitalis)属于另一种泰勒菌,该菌于2001年在2头公驴以及1头母马体内首次分离得到,不具有致病性。
但有研究表明,母马人工感染该菌后会出现子宫炎及宫颈炎等明显临床症状,并且该菌可以在驴体内长期存在,因而其可以被视为潜在病原。
马生殖泰勒菌与该菌存在极其相似的基因库,但两者的基因同源性较小。

CEM主要侵害母马,公马也可感染,但感染后不会出现临床症状,驴通过人工感染后也可发病。
病马和带菌马为该病的主要传染源,尤其是隐性感染的繁殖母马和种公马是最危险的传染源。
该病可以通过自然交配传播,也可通过人工授精过程中污染的精液、器械、人员等进行传播。
2008-2009年美国暴发的病例和2011-2012年期间南非暴发的病例都是由于引进带菌种马并用于人工育种从而导致该病的传播。
除此之外,在对母马生殖道进行检查和清洗过程中也存在感染的可能性。

该病常发生于马匹的配种季节。
该菌定植的主要部位为泌尿生殖膜(尿道窝、尿道窦、尿道末端和阴茎鞘),母马的阴蒂窦与阴蒂窝,但很少存在于子宫内。
感染马匹可以长时间携带此菌,并且间歇性地排菌。
该病于1977年在英国与爱尔兰的纯种马中首次发现。
1977-1978年中,该病迅速在比利时、法国、德国、澳大利亚以及美国等国内传播,并且于1978年在意大利与日本得到首次报道。
近年来,在世界各地也发现存在马传染性子宫炎的散发病例。
2022年2月4日,英国继2021年发现该病后再次通报英格兰发生一起马传染性子宫炎疫情,1匹马感染。
丹麦近几年来也曾多次报道该病的相关疫情情况。迄今为止,我国境内的马属动物暂未检出该疾病。

受感染母马一般不会出现全身临床症状,主要临床表现为子宫颈炎以及早期发情。
正常情况下,母马在交配后第2天会出现轻微的阴道分泌物。
但感染CEM后,母马会产生大量脓性外阴分泌物以及大量黏性子宫分泌物,并且出现严重的宫颈炎或者子宫内膜炎,发情间期缩短,在7或8 d后,即可重新发情。
分泌物量多时,污染臀部、使尾毛缠结,并在会阴部皮肤上结块,量少时,多沉积在阴道底部弯窿内,不呈现外部症状。
Luddys S和KutzlerM A报道称,仅30%~40%的阳性感染母马会出现急性临床症状,而大部分感染母马都属于隐性感染。

大多数母马可以在几周到几个月内能够完全自愈,并且对母马的生育能力无明显影响,自愈后的母马可能为马生殖泰勒菌的携带者,长时间排菌。
与马副伤寒、马传染性鼻肺炎、马病毒性动脉炎以及马媾疫等易引起马流产的传染性疾病不同,妊娠母马感染该菌后,一般能正常分娩,且由于其为生殖道污染,因而会先天性地传播给马驹,使产下幼驹带菌。
种马严格意义上不会感染马生殖泰勒菌,该菌是一种与包皮垢相关的共生菌,因此其会在外生殖器上定居,不会出现临床症状,且不会产生相应抗体。
受感染的种马是该病传播的主要来源之一,携带者会数月甚至数年带菌,并在此期间可感染更多的母马。

症状较轻者,剖检可见子宫轻微肿大,子宫内有少量脓性分泌物。
症状严重者,剖检可见子宫肿胀严重,子宫内以及阴道前庭会出现灰白色脓性渗出物,子宫内膜肥大,有玻璃状外观。
组织病理检查可见子宫内膜上皮细胞呈局部增生,部分上皮细胞呈退行性变化,上皮常见一层条形核白细胞层,基质内出现单核细胞浸润。

细菌的病原学诊断方式主要包括细菌分离鉴定、革兰氏染色、生化特性分析以及血清型检测等。
病原学检查为该菌检测的金标准,被运用于国际贸易与运输检测协议中。
该种方法需从母马子宫颈、尿道、阴道窝与阴道窦,种马尿道、尿道窝与包皮中采集拭子。
在运输过程中,该菌的活力会随着运输时间的增长而降低,并且在高温环境中,此种现象更加明显。
因此,该拭子的运输应该在含活性炭的Amies培养基中,以吸附细菌代谢过程中产生的副产物,运输中需4 ℃保存,并在48 h内接种于相应培养基上。

Duquesne F等通过对比11种培养基在运输过程中对马生殖泰勒菌的活性影响,发现其中一种培养基在该菌的保存与运输方面有很好的应用前景。
即将含50 mL/L马血的琼脂培养基加热至70~80 ℃,持续12 min, 将琼脂冷却至45~50 ℃后,加入甲氧苄氨嘧啶(1 μg/mL),克林霉(5 μg/mL),加入两性霉素B(5~15 μg/mL),此培养基是分离该菌首选的培养基。
其可以抑制许多共生菌以及真菌的生长,同时筛选出链霉素敏感菌及耐药菌。
在上述巧克力琼脂培养基中添加硫酸链霉素(200 μg/mL)可以仅筛选出对链霉素耐药的马生殖泰勒菌。
所有培养基内容物都需要对其添加量进行严格控制并且置于最适生长环境中进行培养,以确保可疑微生物的少量生长。
为确保所用培养条件适合马生殖泰勒菌的正常生长,可将参考菌株与试验样品进行同时培养。

该菌生长缓慢,一般需要72 h后才可见此菌菌落,甚至有的需要14 d才可以观察到菌落。
WOAH建议应该将疑似样品培养7 d以上,才能确认为阴性。
对于有其他细菌污染的培养物,不能够直接发布阴性报告,需要进一步试验进行确认。
一般检测程序为每周采样1次,持续3周,连续3周未分离到病原菌则可判定为阴性。
对于检测为阴性的公马可以进行母马交配试验,从而减少假阴性的可能性。

血清学检测因其操作简单,成本较低且所用检测仪器对专业要求不高的优点,常被用于疾病的诊断。
但对于该病来说,血清学试验只适用于对最近感染的母马进行辅助性检测,种马在感染该菌后不会产生相应抗体,因而不能采用血清学试验进行检测。
通过对受感染母马血清进行补体结合试验,发现受感染母马血清中该细菌补体结合抗体的滴度从感染后7 d上升到3周达到峰值,然后在6~10周呈下降趋势,因此该种方法不适用于感染后期的母马。
目前,对于此病的血清学检测均采用以全菌蛋白作为抗原来对血清中相关抗体含量进行检测。
有研究表明,在2008-2009年美国暴发的病例中,血清学检测结果与细菌培养检查结果仅存在较低的相关性。
迄今为止,已报道的血清学检测方法包括玻板凝集试验、试管凝集试验、补体结合试验、间接血凝试验、酶联免疫吸附试验和间接荧光抗体技术等。
目前,并未发现不同泰勒菌株之间存在血清型差异,马生殖泰勒菌与驴生殖泰勒菌之间会出现血清型上的交叉反应。

CEM的官方检测方法除了细菌培养后进行细菌学检测以外,还可利用分子生物学的方法进行检测,包括PCR、荧光定量PCR、半套式聚合酶链反应(semi-nested PCR ,snPCR)以及环介导等温扩增技术(loop-mediated isothermal amplification, LAMP)。
由于此类方法具有快速、灵敏以及高效的优点,已被视为优于细菌学检查的检测方法。
有研究表明,采用PCR进行检测的检出率比细菌学检查的检出率大约高4%。
在细菌培养过程中,可能会出现杂菌污染或所挑选菌落并非马生殖泰勒菌菌落的情况,因而直接对采样拭子进行PCR鉴定的检出率略高于细菌学检查。

Kinoshita Y等通过对7种马生殖泰勒菌核酸检测的方法进行对比发现,在DNA浓度较低的情况下 ,荧光定量PCR的效果要优于snPCR。
虽然细菌学检查被认为是该菌检测的金标准,但难以对马生殖泰勒菌与驴生殖泰勒菌进行区分,上述绝大多数分子生物学的检测方式可以对两种菌进行区分。
采样拭子存在污染的可能性以及所设计PCR引物的特异性不高会导致PCR鉴定存在假阳性的现象。
目前,新兴分子生物学检测方法,如微滴数字PCR、CRISPR等温扩增技术(CRISPR-AMP)等,都未曾在该菌的检测上得到运用。
由于该菌菌株之间不存在血清学差异,无法进行血清学分型,因而建立了一种基于7对管家基因(gltA、gyrB、fh、shmt、tyrB、adk和txn)的分子分型方法。
迄今为止,基于分子分型的方法对马生殖泰勒菌进行分类,共发现49种类型[28]。

该病目前并没有疫苗,只能依靠加强检疫、早期诊断、及时隔离治疗或者扑杀的方式对该病进行预防。
对于无本病的地区和国家,需要谨慎引进马匹,对引进马匹需进行严格的检疫,严禁从有该病的疫区引进种马。
通过在种马场实施筛检种母马与种公马的方式,可以使该病得到一定的防控,甚至得到净化的效果。
在人工授精时,对所用器械和人员的手进行全面的消毒也是防控该病的关键手段。

一旦发现该病,公马应立即停止配种,相关种马和繁殖母马需要进行检测,按照国家法定的传染病处理方案进行处理。
阳性马匹及时接受治疗后可以恢复。
该病的治疗需要注意局部治疗与全身治疗相结合。
局部治疗可使用洗必泰冲洗生殖道,尤其是阴蒂窝、阴蒂窦和尿道,再使用氨苄西林、新霉素等溶液冲洗子宫。
全身治疗可用氨苄西林、新霉素等抗菌药物肌肉注射。
该病的治愈标准为细菌学检查结果呈现阴性。

马传染性子宫炎是一种传染性较强的生殖系统疾病,该病主要危害繁殖期母马,可造成严重的经济损失,因而该病被WOAH列为必须通报的疫病之一。
该病主要导致繁殖期母马出现脓性子宫炎和间情期缩短的临床现象,公马感染后并不会出现临床症状。
该病无疫苗进行防控,只能通过检疫的手段对其进行控制。
官方推荐的检测方法包括细菌学检查和分子生物学检查,两种方法的检测效率均较高,差异并不明显。
但上述两种检测方法均存在一定不足,在未来有一定的改进空间,提高该病的检测效率很大程度上可以对该病的防控起到至关重要的作用。
该病的病原对大多数的抗菌药物无耐药现象,这使得该病的治疗较为容易。
但治疗后的马匹依旧存在带菌现象,并且可长时间排菌,因此在细菌学检查结果呈现阴性之前,该马匹不能用于繁殖。
该病对母马繁殖造成影响,产生较为严重的经济损失,影响马的国际贸易。
在引进马匹时,做好相应的进口检疫,制定并遵守相应的检疫规定,对阳性马匹进行及时治疗,以期减少和控制马传染性子宫炎的发生与传播。